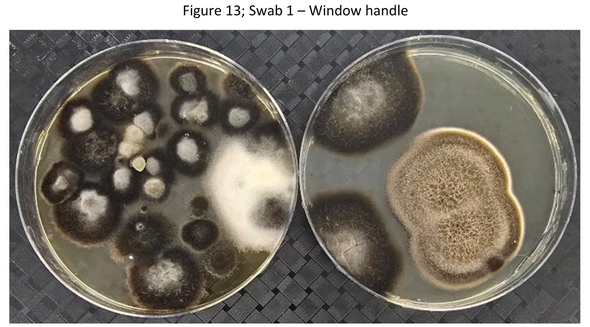

One easy cleansing behavior could possibly be spreading micro organism round your kitchen. One cleansing merchandise you employ on a…
Read More

One easy cleansing behavior could possibly be spreading micro organism round your kitchen. One cleansing merchandise you employ on a…
Read More
EXCLUSIVE: Each house boasts home windows however this surprising examine has discovered they are often tons of of occasions filthier…
Read More